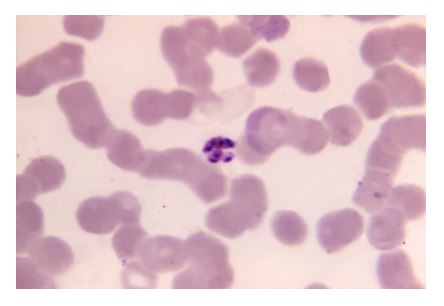
Plasmodium falciparum, here visualized using false-color transmission electron microscopy

Characteristics and Traits
Jung Choi; Mary Ann Clark; and Matthew Douglas
Learning Objectives
By the end of this section, you will be able to do the following:
- Explain the relationship between genotypes and phenotypes in dominant and recessive gene systems
- Develop a Punnett square to calculate the expected proportions of genotypes and phenotypes in a monohybrid cross
- Explain the purpose and methods of a test cross
- Identify non-Mendelian inheritance patterns such as incomplete dominance, codominance, recessive lethals, multiple alleles, and sex linkage
Physical characteristics are expressed through genes carried on chromosomes. The genetic makeup of peas consists of two similar, or homologous, copies of each chromosome, one from each parent. Each pair of homologous chromosomes has the same linear order of genes. In other words, peas are diploid organisms in that they have two copies of each chromosome. The same is true for many other plants and for virtually all animals. Diploid organisms produce haploid gametes, which contain one copy of each homologous chromosome that unite at fertilization to create a diploid zygote.
For cases in which a single gene controls a single characteristic, a diploid organism has two genetic copies that may or may not encode the same version of that characteristic. Gene variants that arise by mutation and exist at the same relative locations on homologous chromosomes are called alleles. Mendel examined the inheritance of genes with just two allele forms, but it is common to encounter more than two alleles for any given gene in a natural population.
Phenotypes and Genotypes
Two alleles for a given gene in a diploid organism are expressed and interact to produce physical characteristics. The observable traits expressed by an organism are referred to as its phenotype. An organism’s underlying genetic makeup, consisting of both physically visible and non-expressed alleles, is called its genotype. Mendel’s hybridization experiments demonstrate the difference between phenotype and genotype. When true-breeding plants in which one parent had yellow pods and one had green pods were cross-fertilized, all of the F1 hybrid offspring had yellow pods. That is, the hybrid offspring were phenotypically identical to the true-breeding parent with yellow pods. However, we know that the allele donated by the parent with green pods was not simply lost because it reappeared in some of the F2 offspring. Therefore, the F1 plants must have been genotypically different from the parent with yellow pods.
The P1 plants that Mendel used in his experiments were each homozygous for the trait he was studying. Diploid organisms that are homozygous at a given gene, or locus, have two identical alleles for that gene on their homologous chromosomes. Mendel’s parental pea plants always bred true because both of the gametes produced carried the same trait. When P1 plants with contrasting traits were cross-fertilized, all of the offspring were heterozygous for the contrasting trait, meaning that their genotype reflected that they had different alleles for the gene being examined.
Dominant and Recessive Alleles
Our discussion of homozygous and heterozygous organisms brings us to why the F1 heterozygous offspring were identical to one of the parents, rather than expressing both alleles. In all seven pea-plant characteristics, one of the two contrasting alleles was dominant, and the other was recessive. Mendel called the dominant allele the expressed unit factor; the recessive allele was referred to as the latent unit factor. We now know that these so-called unit factors are actually genes on homologous chromosome pairs. For a gene that is expressed in a dominant and recessive pattern, homozygous dominant and heterozygous organisms will look identical (that is, they will have different genotypes but the same phenotype). The recessive allele will only be observed as phenotype in homozygous recessive individuals. Examples of dominant and recessive alleles in humans are shown in Table 12.4.
Human Inheritance in Dominant and Recessive Patterns
| Dominant Traits | Recessive Traits |
|---|---|
| Achondroplasia | Albinism |
| Brachydactyly | Cystic fibrosis |
| Huntington’s disease | Duchenne muscular dystrophy |
| Marfan syndrome | Galactosemia |
| Neurofibromatosis | Phenylketonuria |
| Widow’s peak | Sickle-cell anemia |
| Wooly hair | Tay-Sachs disease |
Conventions for Referring to Genes and Alleles
Several conventions exist for referring to genes and alleles. For the purposes of this chapter, we will abbreviate genes most of the time using the first letter of the gene’s corresponding dominant trait. For example, violet is the dominant trait for a pea plant’s flower color, so the flower-color gene would be abbreviated as V (note that it is customary to italicize gene designations). Furthermore, we will use uppercase (V) and lowercase (v) letters to represent dominant and recessive alleles, respectively. Therefore, we would refer to the genotype of a homozygous dominant pea plant with violet flowers as VV, a homozygous recessive pea plant with white flowers as vv, and a heterozygous pea plant with violet flowers as Vv.
Genes can also be named after a mutant phenotype. If the mutant is dominant, then the letter is uppercase. If the mutant is a recessive mutant, then the letter is lowercase. An example is the recessive mutant for white (w) eye color in the fruit fly. Fruit flies with white eyes would be ww. The dominant allele W causes red eyes for flies with WW and Ww, but flies with ww have white eyes (see Figure 12.11 and Figure 12.12). Mutations to X chromosomes are written as superscripts to X chromosome. The white eye mutant is located on the X chromosome. Therefore, some examples of genotypes could be XWXW, XWXw, and XwXw (see Figure 12.11 and Figure 12.12).
The Punnett Square Approach for a Monohybrid Cross
When fertilization occurs between two true-breeding parents that differ in only one characteristic, the process is called a monohybrid cross, and the resulting offspring are monohybrids. Mendel performed seven monohybrid crosses involving contrasting traits for each characteristic. On the basis of his results in F1 and F2 generations, Mendel postulated that each parent in the monohybrid cross contributed one of two paired unit factors to each offspring, and every possible combination of unit factors was equally likely.
To demonstrate a monohybrid cross, consider the case of true-breeding pea plants with yellow versus green pea seeds. The dominant seed color is yellow; therefore, the parental genotypes were YY for the plants with yellow seeds and yy for the plants with green seeds, respectively. A Punnett square, devised by the British geneticist Reginald Punnett, can be drawn that applies the rules of probability to predict the possible outcomes of a genetic cross or mating and their expected frequencies. To prepare a Punnett square, all possible combinations of the parental alleles are listed along the top (for one parent) and side (for the other parent) of a grid, representing their meiotic segregation into haploid gametes. Then the combinations of egg and sperm are made in the boxes in the table to show which alleles are combining. Each box then represents the diploid genotype of a zygote, or fertilized egg, that could result from this mating. Because each possibility is equally likely, genotypic ratios can be determined from a Punnett square. If the pattern of inheritance (dominant or recessive) is known, the phenotypic ratios can be inferred as well. For a monohybrid cross of two true-breeding parents, each parent contributes one type of allele. In this case, only one genotype is possible. All offspring are Yy and have yellow seeds (Figure 12.4).

A self-cross of one of the Yy heterozygous offspring can be represented in a 2 × 2 Punnett square because each parent can donate one of two different alleles. Therefore, the offspring can potentially have one of four allele combinations: YY, Yy, yY, or yy (Figure 12.4). Notice that there are two ways to obtain the Yy genotype: a Y from the egg and a y from the sperm, or a y from the egg and a Y from the sperm. Both of these possibilities must be counted. Recall that Mendel’s pea-plant characteristics behaved in the same way in reciprocal crosses. Therefore, the two possible heterozygous combinations produce offspring that are genotypically and phenotypically identical despite their dominant and recessive alleles deriving from different parents. They are grouped together. Because fertilization is a random event, we expect each combination to be equally likely and for the offspring to exhibit a ratio of YY:Yy:yy genotypes of 1:2:1 (Figure 12.4). Furthermore, because the YY and Yy offspring have yellow seeds and are phenotypically identical, applying the sum rule of probability, we expect the offspring to exhibit a phenotypic ratio of 3 yellow:1 green. Indeed, working with large sample sizes, Mendel observed approximately this ratio in every F2 generation resulting from crosses for individual traits.
Mendel validated these results by performing an F3 cross in which he self-crossed the dominant- and recessive-expressing F2 plants. When he self-crossed the plants expressing green seeds, all of the offspring had green seeds, confirming that all green seeds had homozygous genotypes of yy. When he self-crossed the F2 plants expressing yellow seeds, he found that one-third of the plants bred true, and two-thirds of the plants segregated at a 3:1 ratio of yellow:green seeds. In this case, the true-breeding plants had homozygous (YY) genotypes, whereas the segregating plants corresponded to the heterozygous (Yy) genotype. When these plants self-fertilized, the outcome was just like the F1 self-fertilizing cross.
The Test Cross Distinguishes the Dominant Phenotype
Beyond predicting the offspring of a cross between known homozygous or heterozygous parents, Mendel also developed a way to determine whether an organism that expressed a dominant trait was a heterozygote or a homozygote. Called the test cross, this technique is still used by plant and animal breeders. In a test cross, the dominant-expressing organism is crossed with an organism that is homozygous recessive for the same characteristic. If the dominant-expressing organism is a homozygote, then all F1 offspring will be heterozygotes expressing the dominant trait (Figure 12.5). Alternatively, if the dominant expressing organism is a heterozygote, the F1 offspring will exhibit a 1:1 ratio of heterozygotes and recessive homozygotes (Figure 12.5). The test cross further validates Mendel’s postulate that pairs of unit factors segregate equally.
Visual Connection


In pea plants, round peas (R) are dominant to wrinkled peas (r). You do a test cross between a pea plant with wrinkled peas (genotype rr) and a plant of unknown genotype that has round peas. You end up with three plants, all which have round peas. From this data, can you tell if the round pea parent plant is homozygous dominant or heterozygous? If the round pea parent plant is heterozygous, what is the probability that a random sample of 3 progeny peas will all be round?
Many human diseases are genetically inherited. A healthy person in a family in which some members suffer from a recessive genetic disorder may want to know if they have the disease-causing gene and what risk exists of passing the disorder on to their offspring. Of course, doing a test cross in humans is unethical and impractical. Instead, geneticists use pedigree analysis to study the inheritance pattern of human genetic diseases (Figure 12.6).
Visual Connection

Alternatives to Dominance and Recessiveness
Incomplete Dominance
Mendel’s results, that traits are inherited as dominant and recessive pairs, contradicted the view at that time that offspring exhibited a blend of their parents’ traits. However, the heterozygote phenotype occasionally does appear to be intermediate between the two parents. For example, in the snapdragon, Antirrhinum majus (Figure 12.7), a cross between a homozygous parent with white flowers (CWCW) and a homozygous parent with red flowers (CRCR) will produce offspring with pink flowers (CRCW). (Note that different genotypic abbreviations are used for Mendelian extensions to distinguish these patterns from simple dominance and recessiveness.) This pattern of inheritance is described as incomplete dominance, denoting the expression of two contrasting alleles such that the individual displays an intermediate phenotype. The allele for red flowers is incompletely dominant over the allele for white flowers. However, the results of a heterozygote self-cross can still be predicted, just as with Mendelian dominant and recessive crosses. In this case, the genotypic ratio would be 1 CRCR:2 CRCW:1 CWCW, and the phenotypic ratio would be 1:2:1 for red:pink:white.


Codominance
A variation on incomplete dominance is codominance, in which both alleles for the same characteristic are simultaneously expressed in the heterozygote. An example of codominance is the MN blood groups of humans. The M and N alleles are expressed in the form of an M or N antigen present on the surface of red blood cells. Homozygotes (LMLM and LNLN) express either the M or the N allele, and heterozygotes (LMLN) express both alleles equally. In a self-cross between heterozygotes expressing a codominant trait, the three possible offspring genotypes are phenotypically distinct. However, the 1:2:1 genotypic ratio characteristic of a Mendelian monohybrid cross still applies.
Multiple Alleles
Mendel implied that only two alleles, one dominant and one recessive, could exist for a given gene. We now know that this is an oversimplification. Although individual humans (and all diploid organisms) can only have two alleles for a given gene, multiple alleles may exist at the population level such that many combinations of two alleles are observed. Note that when many alleles exist for the same gene, the convention is to denote the most common phenotype or genotype among wild animals as the wild type (often abbreviated “+”); this is considered the standard or norm. All other phenotypes or genotypes are considered variants of this standard, meaning that they deviate from the wild type. The variant may be recessive or dominant to the wild-type allele.
An example of multiple alleles is coat color in rabbits (Figure 12.8). Here, four alleles exist for the c gene. The wild-type version, C+C+, is expressed as brown fur. The chinchilla phenotype, cchcch, is expressed as black-tipped white fur. The Himalayan phenotype, chch, has black fur on the extremities and white fur elsewhere. Finally, the albino, or “colorless” phenotype, cc, is expressed as white fur. In cases of multiple alleles, dominance hierarchies can exist. In this case, the wild-type allele is dominant over all the others, chinchilla is incompletely dominant over Himalayan and albino, and Himalayan is dominant over albino. This hierarchy, or allelic series, was revealed by observing the phenotypes of each possible heterozygote offspring.

The complete dominance of a wild-type phenotype over all other mutants often occurs as an effect of “dosage” of a specific gene product, such that the wild-type allele supplies the correct amount of gene product whereas the mutant alleles cannot. For the allelic series in rabbits, the wild-type allele may supply a given dosage of fur pigment, whereas the mutants supply a lesser dosage or none at all. Interestingly, the Himalayan phenotype is the result of an allele that produces a temperature-sensitive gene product that only produces pigment in the cooler extremities of the rabbit’s body.
Alternatively, one mutant allele can be dominant over all other phenotypes, including the wild type. This may occur when the mutant allele somehow interferes with the genetic message so that even a heterozygote with one wild-type allele copy expresses the mutant phenotype. One way in which the mutant allele can interfere is by enhancing the function of the wild-type gene product or changing its distribution in the body. One example of this is the Antennapedia mutation in Drosophila (Figure 12.9). In this case, the mutant allele expands the distribution of the gene product, and as a result, the Antennapedia heterozygote develops legs on its head where its antennae should be.


Figure 12.9 Photograph (top image) and schematic (bottom image) of the Antennapedia mutant in Drosophila. The wild-type Drosophila is shown on the left and the Antennapedia mutant on the right. The Antennapedia mutant has legs on its head in place of antennae. Image credit of the cartoon-like schematic. I Tietzel. CC BY SA
Evolution Connection
Multiple Alleles Confer Drug Resistance in the Malaria Parasite

Figure 12.10 The (a) Anopheles gambiae, or African malaria mosquito, acts as a vector in the transmission to humans of the malaria-causing parasite (b) Plasmodium falciparum, here visualized using false-color transmission electron microscopy. (credit a: James D. Gathany; credit b: Ute Frevert; false color by Margaret Shear; scale-bar data from Matt Russell) (c) A 1125X photomicrograph magnification of a Giemsa stained, thin film blood smear, revealed a mature, Plasmodium malariae schizont. Malaria is seen in darker violet color. Original image sourced from US Government department: Public Health Image Library, Centers for Disease Control and Prevention.
In Southeast Asia, Africa, and South America, P. falciparum has developed resistance to the anti-malarial drugs chloroquine, mefloquine, and sulfadoxine-pyrimethamine. P. falciparum, which is haploid during the life stage in which it is infectious to humans, has evolved multiple drug-resistant mutant alleles of the dhps gene. Varying degrees of sulfadoxine resistance are associated with each of these alleles. Being haploid, P. falciparum needs only one drug-resistant allele to express this trait.
In Southeast Asia, different sulfadoxine-resistant alleles of the dhps gene are localized to different geographic regions. This is a common evolutionary phenomenon that occurs because drug-resistant mutants arise in a population and interbreed with other P. falciparum isolates in close proximity. Sulfadoxine-resistant parasites cause considerable human hardship in regions where this drug is widely used as an over-the-counter malaria remedy. As is common with pathogens that multiply to large numbers within an infection cycle, P. falciparum evolves relatively rapidly (over a decade or so) in response to the selective pressure of commonly used anti-malarial drugs. For this reason, scientists must constantly work to develop new drugs or drug combinations to combat the worldwide malaria burden.2
X-Linked Traits
In humans, as well as in many other animals and some plants, the sex of the individual is determined by sex chromosomes. The sex chromosomes are one pair of non-homologous chromosomes. Until now, we have only considered inheritance patterns among non-sex chromosomes, or autosomes. In addition to 22 homologous pairs of autosomes, human females have a homologous pair of X chromosomes, whereas human males have an XY chromosome pair. Although the Y chromosome contains a small region of similarity to the X chromosome so that they can pair during meiosis, the Y chromosome is much shorter and contains many fewer genes. In fact, when Nettie Stevens discovered that the X and Y chromosomes were the determinants of sex, she differentiated them only by size. (Note that in this case and in the description below, the terms X and Y chromosome were not used at the time.) When a gene being examined is present on the X chromosome, but not on the Y chromosome, it is said to be X-linked.
Eye color in Drosophila was one of the first X-linked traits to be identified. Thomas Hunt Morgan mapped this trait to what became known as the X chromosome in 1910. Like humans, Drosophila males have an XY chromosome pair, and females are XX. In flies, the wild-type eye color is red (XW) and it is dominant to white eye color (Xw) (Figure 12.11). Because of the location of the eye-color gene, reciprocal crosses do not produce the same offspring ratios. Males are said to be hemizygous, because they have only one allele for any X-linked characteristic. Hemizygosity makes the descriptions of dominance and recessiveness irrelevant for XY males. Drosophila males lack a second allele copy on the Y chromosome; that is, their genotype can only be XWY or XwY. In contrast, females have two allele copies of this gene and can be XWXW, XWXw, or XwXw.


Figure 12.11 In Drosophila, several genes determine eye color. The genes for white and vermilion eye colors are located on the X chromosome. Others are located on the autosomes. Top panel: Photograph of Drosophila phenotypes for eye color. Clockwise from top left are brown, cinnabar, sepia, vermilion, white, and red. Red eye color is wild-type and is dominant to white eye color. Bottom panel: Schematic diagrams of phenotypes for eye color of Drosophila.
In an X-linked cross, the genotypes of F1 and F2 offspring depend on whether the recessive trait was expressed by the male or the female in the P1 generation. With regard to Drosophila eye color, when the P1 male expresses the white-eye phenotype and the female is homozygous red-eyed, all members of the F1 generation exhibit red eyes (Figure 12.12). The F1 females are heterozygous (XWXw), and the males are all XWY, having received their X chromosome from the homozygous dominant P1 female and their Y chromosome from the P1 male. A subsequent cross between the XWXw female and the XWY male would produce only red-eyed females (with XWXW or XWXw genotypes) and both red- and white-eyed males (with XWY or XwY genotypes). Now, consider a cross between a homozygous white-eyed female and a male with red eyes. The F1 generation would exhibit only heterozygous red-eyed females (XWXw) and only white-eyed males (XwY). Half of the F2 females would be red-eyed (XWXw) and half would be white-eyed (XwXw). Similarly, half of the F2 males would be red-eyed (XWY) and half would be white-eyed (XwY).
Visual Connection

Discoveries in fruit fly genetics can be applied to human genetics. When a female parent is homozygous for a recessive X-linked trait, she will pass the trait on to 100 percent of her offspring. Her male offspring are, therefore, destined to express the trait, as they will inherit their father’s Y chromosome. In humans, the alleles for certain conditions (some forms of color blindness, hemophilia, and muscular dystrophy) are X-linked. Females who are heterozygous for these diseases are said to be carriers and may not exhibit any phenotypic effects. These females will pass the disease to half of their sons and will pass carrier status to half of their daughters; therefore, recessive X-linked traits appear more frequently in males than females.
In some groups of organisms with sex chromosomes, the sex with the non-homologous sex chromosomes is the female rather than the male. This is the case for all birds. In this case, sex-linked traits will be more likely to appear in the female, in which they are hemizygous.
Human Sex-linked Disorders
Sex-linkage studies in Morgan’s laboratory provided the fundamentals for understanding X-linked recessive disorders in humans, which include red-green color blindness, and Types A and B hemophilia. Because human males need to inherit only one recessive mutant X allele to be affected, X-linked disorders are disproportionately observed in males. Females must inherit recessive X-linked alleles from both of their parents in order to express the trait. When they inherit one recessive X-linked mutant allele and one dominant X-linked wild-type allele, they are carriers of the trait and are typically unaffected. Carrier females can manifest mild forms of the trait due to the inactivation of the dominant allele located on one of the X chromosomes. However, female carriers can contribute the trait to their male children, resulting in the male exhibiting the trait, or they can contribute the recessive allele to their female children, resulting in the children being carriers of the trait (Figure 12.13). Although some Y-linked recessive disorders exist, typically they are associated with infertility in males and are therefore not transmitted to subsequent generations.

Lethality
A large proportion of genes in an individual’s genome are essential for survival. Occasionally, a nonfunctional allele for an essential gene can arise by mutation and be transmitted in a population as long as individuals with this allele also have a wild-type, functional copy. The wild-type allele functions at a capacity sufficient to sustain life and is therefore considered to be dominant over the nonfunctional allele. However, consider two heterozygous parents that have a genotype of wild-type/nonfunctional mutant for a hypothetical essential gene. In one quarter of their offspring, we would expect to observe individuals that are homozygous recessive for the nonfunctional allele. Because the gene is essential, these individuals might fail to develop past fertilization, die in utero, or die later in life, depending on what life stage requires this gene. An inheritance pattern in which an allele is only lethal in the homozygous form and in which the heterozygote may be normal or have some altered nonlethal phenotype is referred to as recessive lethal.
For crosses between heterozygous individuals with a recessive lethal allele that causes death before birth when homozygous, only wild-type homozygotes and heterozygotes would be observed. The genotypic ratio would therefore be 2:1. In other instances, the recessive lethal allele might also exhibit a dominant (but not lethal) phenotype in the heterozygote. For instance, the recessive lethal Curly allele in Drosophila affects wing shape in the heterozygote form but is lethal in the homozygote.
A single copy of the wild-type allele is not always sufficient for normal functioning or even survival. The dominant lethal inheritance pattern is one in which an allele is lethal both in the homozygote and the heterozygote; this allele can only be transmitted if the lethality phenotype occurs after reproductive age. Individuals with mutations that result in dominant lethal alleles fail to survive even in the heterozygote form. Dominant lethal alleles are very rare because, as you might expect, the allele only lasts one generation and is not transmitted. However, just as the recessive lethal allele might not immediately manifest the phenotype of death, dominant lethal alleles also might not be expressed until adulthood. Once the individual reaches reproductive age, the allele may be unknowingly passed on, resulting in a delayed death in both generations. An example of this in humans is Huntington’s disease, in which the nervous system gradually wastes away (Figure 12.14). People who are heterozygous for the dominant Huntington allele (Hh) will inevitably develop the fatal disease. However, the onset of Huntington’s disease may not occur until age 40, at which point the afflicted persons may have already passed the allele to 50 percent of their offspring.

Footnotes
- 2 Sumiti Vinayak, et al., “Origin and Evolution of Sulfadoxine Resistant Plasmodium falciparum,” Public Library of Science Pathogens 6, no. 3 (2010): e1000830, doi:10.1371/journal.ppat.1000830.